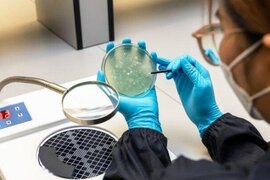
.

Sağlamlıq xəbərləri
İndiyə qədərki ən təhlükəli variant -Dəri ilə təmasda olduqda ötürülür
Ümumdünya Səhiyyə Təşkilatı meymun çiçəyi virusunun (Mpox) yeni variantının Konqo Demokratik Respublikasının şərq sərhədi boyunca sürətlə yayıldığını və "hələ ki, ən təhlükəli variant" olduğunu açıqlayıb. Bu mövcud epidemiya cinsi yolla ötürülmə ilə başladı, lakin bu xəstəliyin dəridən dəriy
6 iyul 2024
Gənclər arasında sürətlə yayılan xəstəlik – SƏBƏB NƏDİR?
Gənc yaşda Parkinson xəstəliyinə tutulma halları artmağa başlayıb. Nevroloq, Dr. Gülten Özdemir yaşlılıqda daha çox rast gəlinən Parkinsonun artıq gəncləri hədəf almasının səbəblərindən danışıb. "Bəzi tədqiqatlar göstərir ki, quyu suyu, insektisidlər, qurğuşun və civə kimi ekoloji toksiklərə məru
6 iyul 2024
İsti havalarda ürək xəstəliklərindən necə qorunaq? - HƏKİM DANIŞDI
Səhiyyə Nazirliyi Elmi-Tədqiqat Kardiologiya İnstitutunun direktor müavini, professor Rafail Daşdəmirov ürək-damar xəstəlikləri barədə danışıb. onunla müsahibəni təqdim edir:. - Rafail müəllim, ilk öncə ürək-damar sistemi xəstəliklərinin yaranma səbəbləri haqqında məlumat verərdiniz. - Ürək-damar sistemini
5 iyul 2024
50 yaşdan sonra qocalmanı necə yavaşlatmaq olar?
Yetkinlik dövründə bədənin zülal və çox miqdarda tərəvəz və meyvələrə ehtiyacı var. Düzgün qidalanma vərdişləri sayəsində 50 ildən sonra qocalma prosesini ləngidə bilərsiniz. Bitki əsaslı qidalara, adekvat protein və lif qəbuluna diqqət yetirmək və ultra işlənmiş qidalardan qaçınmaq vacibdir. xaric
5 iyul 2024
Yaşlı insanlar bu meyvəni yeməlidir – Ürək sağlamlığı üçün faydalıdır
Yayda tərəvəz, meyvə və giləmeyvə yeyərək orqanizminizi dəstəkləyə bilərsiniz. Giləmeyvələrə gəldikdə, bir çox insanlar bunun sadəcə adi çiyələk, qaragilə, yabanı çiyələk və digər bağ bitkiləri olduğunu düşünür. Ancaq əslində daha böyük giləmeyvə var. Həmçinin, onun sağlamlıq üçün də faydaları çoxdur
3 iyul 2024
İtirilmiş dişlərin bərpası mümkün olacaq - Yeni KƏŞF
Yapon alimləri itirilmiş azı dişləri bərpa etmək üçün yeni üsul hazırlayıblar. -a istinadən bildirir ki, tədqiqatçılar təsiredici nəticələr göstərən laboratoriya sınaqlarını uğurla tamamlayıblar. Təcrübələr təsdiq edib ki, hazırkı formula gəmiricilərdə yaxşı mübarizə aparır və yan təsirlərə səbəb olmur
30 iyun 2024
Balıq yağı aqressiyanı effektiv şəkildə azaldır
Pensilvaniya Universitetinin amerikalı alimləri sübut ediblər ki, balıq yağında olan omeqa-3 əlavələrinin istehlakı aqressivliyin orta, lakin əhəmiyyətli dərəcədə azalmasına gətirib çıxarır. "Report" xəbər verir ki, tədqiqat "Aggression and Violent Behavior" (AVB) elmi jurnalınd
30 iyun 2024
50 yaşdan yuxarı insanlar üçün ən sağlam balıq
50 yaşdan yuxarı insanlar öz sağlamlıqlarına xüsusi diqqət yetirməli, sağlam qidalar seçməlidirlər. Belə qidalardan biri balıqdır, lakin ən qidalı növünü tapmaq bəzən çətin ola bilər. -a istinadən bildirir ki, yaşlı insanlar zülallı qidalar seçərkən balığa üstünlük verməlidir. Ən faydalı balıq növlərində
30 iyun 2024
Yaşanmış travmalar beyindəki sinir əlaqələrinin sistemini pozur
Qərbi Ontario Universitetinin kanadalı alimləri müəyyən ediblər ki, dissosiativ posttravmatik stress pozğunluğu (dPTSD) olan xəstələr sağlam insanlarla müqayisədə beyin fəaliyyətinin fərqli nümunələri göstərirlər. "Report" xəbər verir ki, tədqiqat "Nature Mental Health" elmi jurnalınd
30 iyun 2024
Göbələyin hansı fayda və zərərləri var?
"Göbələk mədə xorası, bağırsaq xəstəlikləri, böyrək və qaraciyər çatışmazlığı olan insanlar üçün əks göstərişdir". Bu barədə rusiyalı həkim Nadejda Podkorytova məlumat verib. "Mədə-bağırsaq xəstəlikləri zamanı göbələk yemək olmaz. Əlavə olaraq allergiya xəstələri də bu məhsuldan çəkinməlidirlər"
30 iyun 2024
Hər gün qarpız yeməyin xeyri
Yay mövsümü meyvələrlə zəngin olur. İsti havaların vazgeçilməz meyvəsi isə qarpızdır. Qarpız həm susuluğu yatızdırır, həm də min bir dərdin dərmanıdır. Axşam.az xəbər verir ki, qarpızın saymaqla bitməyən faydaları var. 1. Qarpız immuniteti gücləndirir. yay qripindən qorunmaq istəyənlər tez-tez qarpı
30 iyun 2024
Yeniyetmələrdə yüksək qan təzyiqi yaranmasının SƏBƏBLƏRİ
Araşdırmalara görə, xroniki yuxu çatışmazlığından əziyyət çəkən uşaqlar və yeniyetmələrdə yüksək qan təzyiqi inkişaf riski arta bilər. Alimlərin bu işi gənclərin orqanizminə uzunmüddətli təsirləri olan, gələcəkdə mümkün ağır problemlərə zəmin yaradan gizli təhlükəni üzə çıxarıb. Araşdırmaya yüksək qa
30 iyun 2024
Dənizə gedəndə BU SAATLARA diqqət edin!
"Çimərliyə getmək üçün ən optimal vaxt səhər 8:00-11:00 arası və axşam saat 17:00-dan sonradır". xəbər verir ki, bu fikirləri "Sağlam radio"da yayımlanan "Sağlam səhər" verilisində Səhiyyə Nazirliyi K.Y.Fərəcova adına Elmi-Tədqiqat Pediatriya İnstitutunun həkim-pediatr
30 iyun 2024
Tənginəfəs olursunuzsa, bunu oxuyun
Yay, qış fərqi yoxdur, həmişə nəfəs yollarımda problemlər yaranır. Təmiz havaya çıxanda belə hava çatışmır kimi hal yaşaya bilərsiniz. Axşam.az xəbər verir ki, tənginəfəslik ağciyər emfizemasının göstəricisidir. Ağciyər emfizeması zamanı ağciyərin toxumalarının hərəkətliyi düşür, havalılıq yüksəlir
29 iyun 2024
ÜST-dən hamilə qadınlara XƏBƏRDARLIQ: "Sağlamlığınız risk altındadır"
Get-gedə süd, süd məhsulları və balıq kimi əsas yod mənbələrini digər qidalar əvəzləyir. Bu da öz növbəsində, xüsusilə hamiləlik dövründə qadınların sağlamlıq risklərini artırır. Bu, Ümumdünya Səhiyyə Təşkilatının (ÜST) Avropa Regional Bürosunun və Yod Qlobal Şəbəkəsinin pəhrizdəki dəyişikliklərlə əlaqəda
29 iyun 2024
Niyə həkim resepti olmadan antibiotik qəbul etmək olmaz? – 3 ƏSAS SƏBƏB
Mütəxəssislər həkim məsləhəti olmadan antibiotic qəbul etməyin zərərlərini açıqlayıb. xarici mətbuata istinadən xəbər verir ki, həkim xəstəliyin klinik mənzərəsini və xəstənin bədəninin xüsusiyyətlərini nəzərə alaraq antibiotiklər təyin edir. Müalicə rejimi test nəticələrinə əsasən müəyyən edilir v
29 iyun 2024
Fitoterapevt Dr Elnur Rəhimov dərmansız müalicə
Dərmanlardan bezmisinizmi? Xəstəliklər əl çəkmirsə Bədənin müqavimətini artırmaq istəyirsinizmi?. TƏBİİ YOLLA MÜALİCƏ SİZİ GÖZLƏYİR. Qədim xalq təbabəti və müasir fitoterapiya üsullarından istifadə , Sınanılmış reseptlərlərlə. Fitoterapevt Dr Elnur Rəhimov sizə xəstəliklərlə ən təbii üsullarla müalic
29 iyun 2024
Qızmar havalarda soyuq su ilə duş almaq ürəyə zərərlidir - Kardioloqdan AÇIQLAMA
İsti havalarda sərinləmək üçün soyuq su ilə duş almaq ürək sağlamlığına mənfi təsir göstərə bilər. xəbər verir ki, bunu Trakya Universiteti (TU) Tibb Fakültəsi Kardiologiya kafedrasının müdiri Prof. Dr. Servet Altay bildirib. "İsti havalarda bədən temperaturunun tarazlığını qorumaq üçün müxtəli
25 iyun 2024
Autizmin ilkin əlamətləri açıqlandı
Autizmin ilk əlamətlərindən biri embrion inkişafı zamanı beynin həddindən artıq böyüməsidir. Bu nəticəyə San Dieqodakı Kaliforniya Universitetinin amerikalı nevroloqları və digər ölkələrdən olan həmkarları gəliblər. Komanda xəstəlikdən əziyyət çəkən 10 körpənin və altı sağlam uşağın qanından kök hüceyr
23 iyun 2024
Ölümcül bakteriyalarla bağlı XƏBƏRDARLIQ: insanı 48 saatda öldürür
Yaponiyada səlahiyyətlilər "ət yeyən" bakteriyaların səbəb olduğu və potensial ölümcül hesab edilən streptokok zəhərli şok sindromu (STSS) hallarının sayının indiyə qədər ən yüksək səviyyəyə çatdığını bildiriblər. -a istinadən xəbər verir ki, insanların ehtiyat tədbirləri görmələri üçün xəbərdarlı
23 iyun 2024
Qarpızı kəsəndə bu baş verirsə... - Zəhərlidir, yeməyin
Qarpız ən çox istehlak edilən yay meyvələrindən biridir. Həm sağlam, həm də təravətləndirici qida olan qarpız xüsusilə yüngül qəlyanaltı istəyənlər üçün ideal meyvə kimi tanınır. Ancaq hər yay qarpızdan zəhərlənmələr baş verir. Bəs qarpız istehlak edərkən nələrə diqqət etməlisiniz?. -a istinadən xəbə
23 iyun 2024
Bu maddə infarkt riskini artırır: saqqız və diş pastasında da var
Saqqız və diş pastasının tərkibindəki maddə infarkt riskini, həm də hazırkı qlükoza səviyyəsini min dəfə artırır. Həmin maddə diabet xəstələrinin və ya arıqlamaq istəyənlərin istifadə etdiyi ksilitol, saqqız, diş pastası kimi məhsullarda da var. Həmin araşdırma "European Heart Journal" jurnalınd
23 iyun 2024
Niyə yaşlı insanlar çörək yeməməlidirlər?
İnsan nə qədər yaşlıdırsa, məhsul seçimində bir o qədər diqqətli olmalıdır. Qidalanma mütəxəssisləri deyirlər ki, çörək və digər taxıl məhsulları yemək yaşlı insanlar üçün təhlükəli ola bilər. 60 yaşdan sonra ya bu qidalardan tamamilə imtina etmək, ya da onların rasionda miqdarını əhəmiyyətli dərəcəd
23 iyun 2024
Günəşdən qoruyan kremlər dəri xərçənginə səbəb olur? - Dermatoloqdan AÇIQLAMA
Yay fəslinin aktual mövzularından biri də günəş şüalarından yararlanmaqla yanaşı, onun yaratdığı fəsadlardan qorunmaqdır. Çünki son zamanlar dəri xərçənginin (melanoma) çox yayılması ilə bağlı məlumatlara rast gəlinir. Bəziləri bunu dəriyə mənfi təsir edən günəş şüalarında, bəziləri isə dərini qoruma
22 iyun 2024
Bunlar panik-atak əlamətidir
Panik atak insanların həyatına birbaşa təsir edən, bəzilərində isə həyatı yaşanmaz hala gətirən xəstəlikdir. Bu xəstəliyin simptomları çoxdur və hər bir insanda müxtəlif formada biruzə verir. Axşam.az xarici KİV-nə istinadən bildirir ki, qızartı, üşümək, qorxu, başgicəllənmə, səbəbsiz yerə ürəyin sürətl
22 iyun 2024
Bəzi AĞRIKƏSİCİLƏR ağrını daha da artıra bilər - Terapevtdən AÇIQLAMA
Gündəlik həyatımızda ən adi ağrılarda belə ağrıkəsicilərə üz tutmaq adət halı alıb. Amma araşdırmalar onu göstərir ki, əlçatan, reseptsiz satılan bu dərmanlar ağrıların qarşısını tez bir zamanda alsa da, insan orqanizminə fəsadsız ötüşmür. Xeyrindən çox, ziyanı olan ağrıkəsicilərin həkim məsləhəti olmada
22 iyun 2024
Yeni virus dünyada sürətlə inkişaf edir - Səbəbi AÇIQLANDI
Bu virus planetin bütün qitələrinə çatıb və quşları, məməliləri və insanları təhdid edir. Koronavirus pandemiyasından – H5N1 "quş qripi" virusundan hələ də sağalmamış bəşəriyyəti yeni təhlükə gözləyir. -ın xarici mediaya istinadən məlumatına görə, bir çox ölkələrdə aktiv şəkildə yayılmağa başlayı
22 iyun 2024
Qarpızı çox yeməyin, yoxsa...
Dietoloq Yuliya Zinçenko qarpızın çəkiniz üçün təhlükələrini açıqlayıb. xarici mətbuata istinadən xəbər verir ki, mütəxəssisin fikrincə, qarpız insulin müqavimətinə səbəb ola bilər:. "Qarpızı çox miqdarda yedikdə saxaroza və fruktoza bolluğu qanda qlükoza səviyyəsi kəskin şəkildə artır. Bu, insulini
21 iyun 2024
Kefir bu xəstəliklərin qarşısını ala bilər - HƏKİM
Kefir təkcə dadlı deyil, həm də bir çox müalicəvi xüsusiyyətlərə malik olan sağlam pəhriz içkisidir. Gündəlik kefir istehlakı bədəndə müsbət dəyişikliklər edə bilər. -a istinadla kefirin gündəlik istehlakının müsbət tərəflərini təqdim edir:. İmmunitet sisteminin gücləndirilməsi. Kefirin tərkibində immunitet
16 iyun 2024
Yayın sevimlisi qarpızın inanılmaz faydaları
Yay fəslinin əvəzolunmaz meyvələrindən biri olan qarpız bir çoxumuzun sevimlisidir. Bu giləmeyvə həm də insan orqanizmi üçün çox faydalıdır. Bəs görəsən, qarpızın bədənə nə kimi faydaları var?. -a istinadla qarpızın faydalarını təqdim edir:. Qarpız PP, C, D, B1, B2, B6 vitaminləri, dəmir, mis, sink
16 iyun 2024
ŞAD XƏBƏR - Bu tarixdən bütün növ əmək pensiyaları artacaq
Sahili olmayan cəmi bir dəniz var: Harda yerləşir?
Sabah leysan xarakterli yağış yağacaq - HAVA PROQNOZU
Arif Babayevin məzarından GÖRÜNTÜ - VİDEO
"Sədərək"də fəhlə bankomatdan sahibkarın pullarını oğurladı
Dəm qazının qurbanı olan 18 yaşlı Leylinin - Fotoları
Bu doğum tarixləri "qızıl illər" hesab olunur
Ziya Məmmədovun səs-küylü tələbə yoldaşının oğlu - Yarım milyon mənimsəyib
Çox öskürmək ziyandır
Bakıda yeraltı keçiddə eskalator qırıldı - Xəsarət alanlar var
İşçiləri aparan mikroavtobus aşdı: 12 nəfər yaralandı (YENİLƏNİB)
Doğum evindən maraqlı addım - Foto
Röya: "Adımı çəkmədi, ondan umdum"
Sabah Bakıda leysan olacaq - Xəbərdarlıq
"Oğlum hələ uşaq idi, meyiti yox etməli idik..." - Tanınmış həkimin qızı
